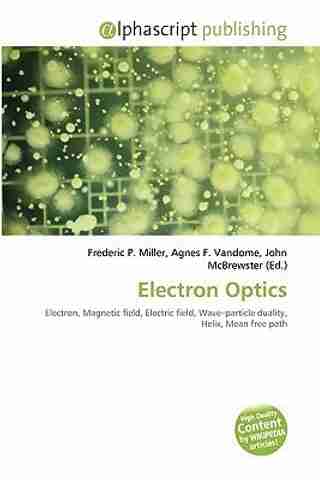
Image

Electron Optics
Alphascript Publishing Electron Optics (English, Paperback, unkno...more
Delivery details
Product highlights
Imprint
Alphascript Publishing
Width
5 mm
Height
152 mm
Length
229 mm
Weight
136 gr
All details
Features, description and more
Manufacturer info
Show More
Hang on, loading content